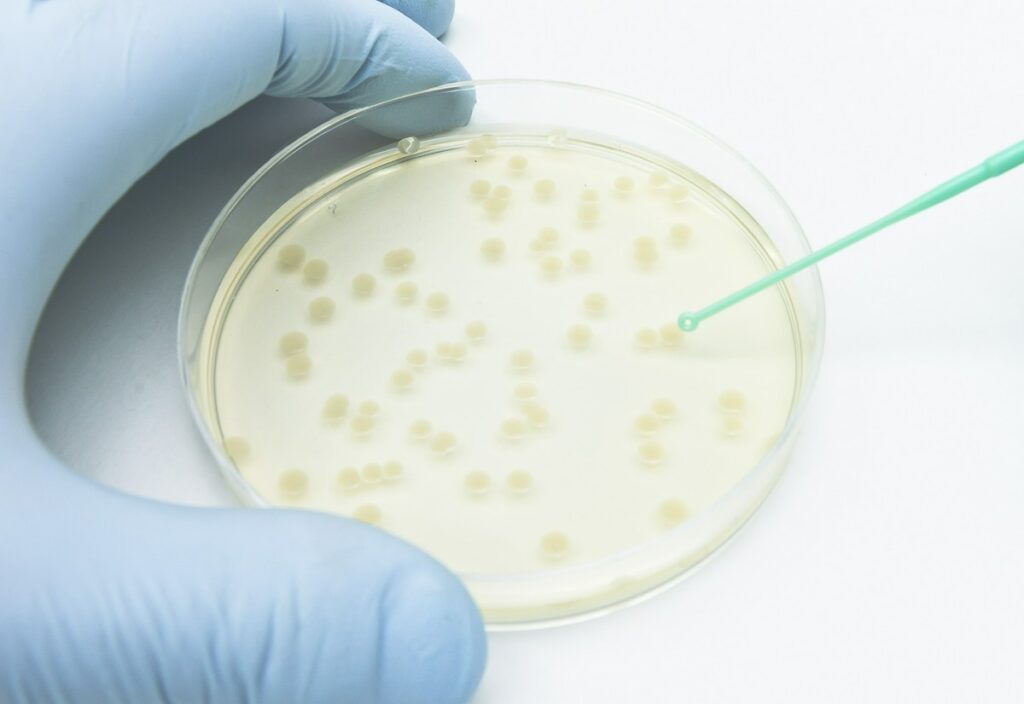
36bb3388-981c-48ae-8ca2-5818f1d419af1-1024x704

Pasożyty to organizmy, które mogą zagnieżdżać się w ciele człowieka, wykorzystując go jako źródło pożywienia i środowisko do rozwoju. Do zakażenia dochodzi najczęściej poprzez spożycie zanieczyszczonej żywności lub wody, kontakt z zabrudzonymi powierzchniami, a także w wyniku niewłaściwej higieny. Ich obecność w organizmie często pozostaje niezauważona przez długi czas, ponieważ objawy mogą być niespecyficzne i przypominać inne schorzenia, takie jak alergie, choroby układu pokarmowego czy przewlekłe zmęczenie. Warto jednak zwrócić uwagę na pewne symptomy, które mogą sugerować zakażenie i skłonić do wykonania odpowiednich badań diagnostycznych.
Jakie dolegliwości ze strony układu pokarmowego mogą sugerować infekcje pasożytnicze?
Infekcje pasożytnicze bardzo często manifestują się poprzez przewlekłe dolegliwości ze strony układu pokarmowego. Do najczęstszych objawów pasożytów należą nudności, biegunki, bóle brzucha, wzdęcia oraz nawracające zaparcia. Symptomy te mogą pojawiać się okresowo lub utrzymywać się przez dłuższy czas, co sprawia, że bywają mylone z zespołem jelita drażliwego lub nietolerancjami pokarmowymi. Charakterystycznym sygnałem ostrzegawczym jest ich przewlekły charakter oraz brak poprawy mimo stosowania standardowego leczenia. Pasożyty mogą również powodować nagły lub stopniowy spadek masy ciała, wynikający z zaburzeń wchłaniania składników odżywczych, witamin i minerałów w jelitach.
Jakie inne sygnały mogą wskazywać na obecność pasożytów?
Oprócz dolegliwości ze strony układu pokarmowego infekcje pasożytnicze mogą powodować ogólne osłabienie organizmu i pogorszenie samopoczucia. Osoby zakażone często odczuwają przewlekłe zmęczenie, mimo odpowiedniej ilości snu. Charakterystyczne mogą być również zaburzenia snu, w tym trudności z zasypianiem lub częste wybudzanie się w nocy, co bywa związane z aktywnością pasożytów. Zmiany skórne, takie jak wysypki, świąd, zaczerwienienie czy pokrzywka, również mogą sygnalizować obecność pasożytów, zwłaszcza gdy mają charakter nawracający. Kolejnym objawem jest niedokrwistość, ponieważ niektóre pasożyty żywią się krwią gospodarza lub prowadzą do niedoborów żelaza i witamin z grupy B.
Jakie inne objawy można łatwo przeoczyć?
Niektóre symptomy infekcji pasożytniczych są na tyle subtelne, że łatwo je zbagatelizować lub przypisać innym przyczynom. Brak apetytu lub jego znaczne obniżenie często nie budzi niepokoju, zwłaszcza w okresach stresu. Pasożyty mogą także wpływać na funkcjonowanie układu nerwowego, powodując drażliwość, wahania nastroju, trudności w koncentracji oraz częste bóle głowy. Objawy te bywają mylone z przemęczeniem lub problemami natury psychicznej, co opóźnia właściwą diagnozę.
Podsumowując, infekcje pasożytnicze mogą manifestować się na wiele różnych sposobów i dotyczyć różnych układów organizmu. Przewlekłe dolegliwości ze strony układu pokarmowego, spadek masy ciała, osłabienie, zaburzenia snu, zmiany skórne, niedokrwistość oraz objawy neurologiczne to tylko niektóre z możliwych sygnałów ostrzegawczych. W przypadku ich wystąpienia warto zachować czujność i skonsultować się z lekarzem, który zleci odpowiednie badania i wdroży właściwe postępowanie diagnostyczne.
FAQ
Jakie są najczęstsze objawy zakażenia pasożytami?
Do typowych objawów należą przewlekłe dolegliwości żołądkowe, takie jak bóle brzucha, biegunki, wzdęcia oraz zmiany skórne i zmęczenie.
Co może prowadzić do zakażenia pasożytami?
Zakażenie najczęściej następuje poprzez spożycie zanieczyszczonej żywności lub wody, kontakt z zabrudzonymi powierzchniami oraz niewłaściwą higienę.
Czy pasożyty mogą wpływać na nastrój i samopoczucie?
Tak, pasożyty mogą powodować drażliwość, wahania nastroju oraz trudności z koncentracją, co bywa mylone z innymi problemami zdrowotnymi.